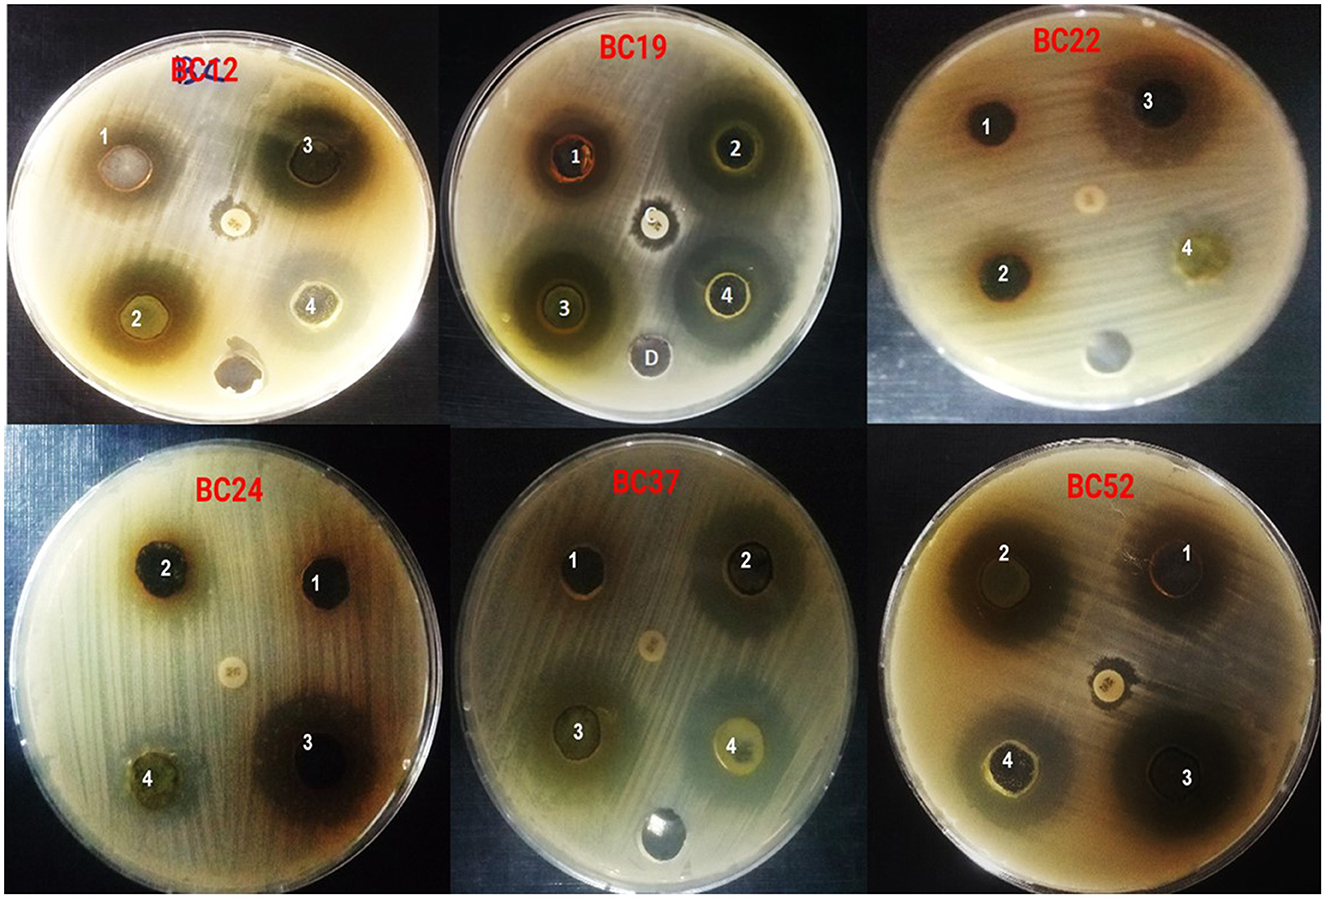
Six petri dishes labeled BC12, BC19, BC22, BC24, BC37, and BC52, each containing four numbered sections. The dishes display varying levels of bacterial growth inhibition around each section. The background is a dark surface.

- 1Clinical Laboratory Science Department, Applied Medical Science College, University of Ha'il, Hail, Saudi Arabia
- 2Botany and Microbiology Department, Faculty of Science, Al-Azhar University, Cairo, Egypt
- 3Clinical Nutrition Department, Applied Medical Science College, University of Ha'il, Hail, Saudi Arabia
- 4Biochemistry Department, College of Medicine, University of Ha'il, Hail, Saudi Arabia
- 5Clinical Pathology Department, National Cancer Institute, Cairo university, Cairo, Egypt
- 6Basic Sciences Department, First Year of Health and Medical Colleges, University of Ha'il, Hail, Saudi Arabia
Introduction: Bacillus cereus (B. cereus) is widely distributed in natural environments, particularly in soil and plant matter, and is frequently linked to foodborne illness outbreaks, accounting for approximately 1.4%–12% of food poisoning cases worldwide. This study aimed to assess the presence of toxigenic and emetic genes among B. cereus isolates, evaluate their antibiotic susceptibility, and investigate the antimicrobial potential of Artemisia vulgaris (A. vulgaris) extract.
Methods: Polymerase chain reaction (PCR) was employed to detect toxigenic and emetic genes in B. cereus isolates. Antibiotic susceptibility was tested against a panel of agents. The antimicrobial, antibiofilm, antioxidant, cytotoxic, and gene-suppressing activities of methanolic A. vulgaris extract were evaluated using standard microbiological, biochemical, and molecular assays. GC-MS and HPLC analyses were performed to identify major bioactive compounds.
Results: PCR revealed that the isolates harbored hemolysin BL (HBL) genes hblA (8.62%) and hblB (20.68%), non-hemolytic enterotoxin (NHE) genes nheA (20.68%) and nheB (22.41%), as well as bceT (29.30%) and ces (15.51%) genes associated with emetic toxin production. Antibiotic testing showed high sensitivity to ciprofloxacin (91.37%) and rifampicin (96.54%), but strong resistance to ampicillin (86.20%) and novobiocin (65.51%). A. vulgaris extract demonstrated potent antibacterial activity (inhibition zones: 19.20 ± 0.25 mm to 27.10 ± 0.13 mm; MICs: 62.5–250 μg/mL), significantly inhibited biofilm formation, and downregulated toxigenic genes by −2.5 to −5.2 fold (***P < 0.0001). The extract also displayed strong antioxidant activity (IC50: 12.7 μg/mL, DPPH; 14.2 μg/mL, ABTS) and low cytotoxicity (IC50: 524.7 ± 1.23 μg/mL, Vero cells; 236.5 ± 1.74 μg/mL, HFB4 cells). GC-MS identified dopamine N,N-dimethyl-dimethyl ether (40.31%) and n-hexadecanoic acid (16.57%) as major compounds, while HPLC revealed high levels of chlorogenic acid, luteolin, and quercitrin.
Discussion/conclusion: These findings highlight the public health risks posed by toxigenic B. cereus in food contamination. The methanolic extract of A. vulgaris exhibits strong antibacterial, antibiofilm, antioxidant, and gene-suppressing activities, supporting its potential as a natural therapeutic strategy against B. cereus and its virulence factors.
1 Introduction
Bacillus cereus is a motile, rod-shaped bacterium that is Gram-positive and can thrive in both aerobic and facultatively anaerobic conditions (Bottone, 2010). B. cereus is categorized within the B. cereus sensu lato group, which includes other bacteria such as B. anthracis, B. thuringiensis, B. mycoides, B. pseudomycoides, B. weihenstephanensis, B. cytotoxicus, and B. toyonensis, as well as several newly discovered species identified through modern genetic taxonomic research, including B. gaemokensis, B. manliponensis, and B. bingmayongensis. A significant genetic resemblance is observed among these bacterial species (Enosi Tuipulotu et al., 2021). Due to the significant differences in the growth and survival characteristics of B. cereus strains, they are classified into two groups: mesophilic and psychrotrophic. The psychrotrophic strains thrive at temperatures below 10 °C, but they do not perform well at 37 °C. These strains may sometimes be found in fresh foods, although they are more commonly observed in cold dishes. In contrast, mesophilic strains can endure temperatures below 10 °C and prosper at 37 °C (Webb et al., 2019).
Through the production of endospores and the formation of biofilms, B. cereus is capable of surviving and flourishing in challenging environments. The elongated spores of B. cereus are encased by a peptidoglycan cortex, an inner membrane, an outer coat, and an inner coat. These bacterial spores, which exhibit resistance to heat, freezing, desiccation, gamma radiation, and UV radiation, remain metabolically inactive. Their remarkable resilience to environmental factors that typically eliminate vegetative bacteria enables them to withstand the emergence of more favorable conditions (Bressuire-Isoard et al., 2018; Kailas et al., 2011; Duport et al., 2016). They also facilitate adherence to human epithelial cells. Both living tissues and non-living surfaces can sustain B. cereus biofilms, which may also manifest as floating pellicles. These biofilms are linked to nosocomial bacteremia and have been observed on central venous catheters. Notably, in contrast to planktonic cells, B. cereus within biofilms produces a greater quantity of secondary metabolites, including catalase and superoxide dismutases, thereby enhancing the bacteria's resistance to host immune responses (Vidic et al., 2020; Ikram et al., 2019; Caro-Astorga et al., 2020).
Food poisoning incidents, which generally appear as emetic and/or diarrheal syndromes, can result from the contamination of food products by bacteria associated with the B. cereus group (Gdoura-Ben Amor et al., 2019; Bennett et al., 2013; Stenfors Arnesen et al., 2008). Consuming cereulide, a preformed toxin present in tainted food, is linked to the emetic form of food poisoning. The ces gene encodes this toxin, a cyclic dodecadepsipeptide that is stable in the face of heat and pH changes and resistant to proteolytic enzymes, which keeps it active throughout the gastrointestinal tract. One or more heat-labile enterotoxins generated in the small intestine are responsible for the diarrheal form of food poisoning (Ceuppens et al., 2012; Hwang and Park, 2010). NHE, encoded by nheA, nheB, and nheC; HBL encoded by hblA, hblB, hblC, and hblD; and cytotoxin K, encoded by cytK, are the enterotoxins associated with B. cereus group bacteria that are mostly in charge of diarrheal illnesses (Gdoura-Ben Amor et al., 2019; Zhang et al., 2015). Guinebretiere et al. (2006) and Castiaux et al. (2015), have reported two different forms of CytK, which they have named cytK-1 and cytK-2. Despite having an 89% protein sequence similarity to CytK-2, CytK-1 is much more hazardous. Among the diarrhoeal enterotoxins include enterotoxin T, which is encoded by the bceT gene, in addition to HBL, NHE, and CytK. Subsequent research has raised questions about the activity and classification of bceT enterotoxin as an enterotoxin, and its function in food poisoning has not been proven (Gdoura-Ben Amor et al., 2019; Choma and Granum, 2002; Hansen et al., 2003). The bceT gene's product has been hypothesized to be a cloning artifact because it has no biological function and does not cause epidemics. The degree of virulent gene expression determines the true risk of food poisoning linked to the B. cereus group. Bacterial cell concentrations of 5 to 8 log10 CFU/g and 5 to 7 log10 CFU/g, respectively, can cause diarrheal and emesis symptoms. As a result, food manufacturers are generally advised to classify foods that contain 105 CFU/g of B. cereus as unfit for human consumption (Gdoura-Ben Amor et al., 2019; Ceuppens et al., 2011). B. cereus-related food poisoning outbreaks have been reported globally. In the European Union, B. cereus toxins were identified as the leading cause of food poisoning outbreaks in 2020, leading to 71 outbreaks, 835 cases, 10 hospitalizations, and one fatality. In Southern Brazil, B. cereus was the predominant pathogen associated with foodborne illnesses from 2003 to 2013. In China, B. cereus emerged as one of the most frequently confirmed pathogens responsible for foodborne outbreaks in recent years. On May 12, 2021, an outbreak of gastrointestinal illness was documented in two middle schools located in a rural region of Chongqing, China. Over one hundred students from both schools exhibited symptoms of vomiting and nausea, which prompted the Chongqing Center for Disease Control and Prevention (CDC) and the local CDC to initiate an investigation and implement necessary control measures (Li et al., 2023).
A. vulgaris belongs to the Compositae family and historically has been extensively employed in various cultures owing to its anthelmintic, antiseptic, antimicrobial, antidiabetic, antidepressant, and vermicidal attributes (Pandey et al., 2017). A diverse range of bioactive secondary metabolites, including essential oils, flavonoids, triterpenes, and coumarin, constitute the primary components of the A. vulgaris. The essential oils derived from A. vulgaris exhibited an inhibition zone measuring 15 mm against Acinetobacter baumannii ATCC 19606, 12 mm against Klebsiella pneumonia ATCC 700603, and 11 mm against Staphylococcus aureus ATCC 43300 (Sharma, 2023). A. vulgaris essential oil showed antibacterial activity against S. aureus (ATCC 25923) and B. cereus (ATCC 13061). For B. cereus and S. aureus, the essential oil's MIC and minimum bactericidal concentration (MBC) were found to be 0.3% and 0.63%, respectively (Singh et al., 2023).
Although several research studies have explored the antimicrobial characteristics of A. vulgaris, this study is unique as it represents the first instance of its application against B. cereus and the risks it poses. This pioneering approach may open new avenues for developing natural antimicrobial agents, potentially reducing reliance on synthetic alternatives. As the prevalence of antibiotic resistance grows, findings from this research could be crucial in shaping future therapeutic strategies. Therefore, the purpose of this study was to assess the toxigenic characteristics of B. cereus isolates and potential fighting with A. vulgaris extract as a promising alternative approach.
2 Materials and methods
2.1 Chemicals and reagents
The culture media, including Muller Hinton broth (MHB) and Muller Hinton agar (MHA), were purchased from Himedia (India), while chemicals and reagents, including methanol, chloroform, ethyl acetate, and antioxidant materials, including diphenyl-1-picrylhydrazyl (DPPH), 2,2′-azino-bis [3-ethylbenzothiazoline-6-sulfonic acid (ABTS)], potassium persulfate, and ascorbic acid, were obtained from Sigma-Aldrich in St. Louis, MO, USA.
2.2 Plant material
A. vulgaris leaves were obtained from a local market in Ha'il, Saudi Arabia, in March 2025. The leaves were thoroughly washed under running tap water to remove any impurities, followed by rinsing with distilled water. They were then placed on clean paper towels and left to dry at 25 ± 2 °C for three days. After drying, the leaves were ground into a fine powder using a high-speed blender for 5 min. The resulting powder was passed through a 40-mesh sieve to ensure uniform particle size. A total of 400 g of powdered A. vulgaris leaves were divided into four equal portions of 100 g each. Each individual portion of 100 g was extracted separately using a single solvent (the first portion was extracted with 500 ml of methanol, the second portion with 500 ml of water, the third portion with 500 ml of chloroform, and the fourth portion with 500 ml of ethyl acetate), utilizing a Soxhlet apparatus (Model No. 3840, Borosil Glass Works Ltd., Mumbai, India) at a temperature of 50 °C for a duration of 8 h. The extracts were then filtered through Whatman No. 1 filter paper, and the solvents were evaporated under reduced pressure using a rotary vacuum. The remaining extracts were dried and stored at −4 °C in a refrigerator for subsequent studies.
2.3 B. cereus isolates
Fifty-eight B. cereus isolates were isolated from various samples, including cereals, spices, canned goods, pastry items, and fresh-cut vegetables, purified, and identified using the Vitek2 system (GP-card) Version 05.04, produced by BioMerieux SA, France. These isolates were obtained from the bacteriology laboratory at the Faculty of Science, Al-Azhar University, Cairo, Egypt.
2.3.1 DNA extraction
For DNA extraction, the B. cereus isolates were cultivated on MHB medium for 20 h at 30 °C without stirring. A 15 ml Falcon tube containing 300 μl of a 25% (m/v) sterile Chelex bead solution (Saint-Herblain, France) made in sterile Milli-Q water (Sigma Aldrich) was then filled with 5 ml of each culture bacterial isolate. After vortexing, the mixture was centrifuged for 7 min at 4 °C at 7,000 rpm. After that, the cell pellet was resuspended in 200 μl of sterile Milli-Q water and heated for 10 min at 100 °C to lyse it. One hundred and fifty microliter of the supernatant was taken and centrifuged again under the same condition following a second centrifugation at 7,000 rpm for 7 min at 4 °C (Walsh et al., 1991). A NanoDrop ND-1000 spectrophotometer (Nanodrop Technologies, Wilmington, USA) was used to measure DNA concentration. The sample was then diluted until it reached a final concentration of about 100 ng/μl.
2.3.2 Detection of toxigenic genes
The emetic (ces) and enterotoxigenic genes (hblA, hblB, nheA, nheB, and bceT) were investigated in the B. cereus isolates. The primers were employed with their annealing temperatures, and amplified fragments for each gene are presented in Table 1. Each reaction mixture contained 5 μl of 100 ng DNA template, 2 μl of each primer (Sigma Aldrich) at a concentration of 10 μM, 0.3 μl of Taq polymerase (5,000 U/ml) (Biolabs, Evry, France), 0.5 μl of 10 mM deoxyribonucleotide triphosphate (Eurogentec, Seraing, Belgium), 1.12 μl of 50 mM MgCl2 (Biolabs), 2.5 μl of 10X AmpliTaq buffer (Biolabs), and 14.5 μl of sterile Milli-Q water. Thermocycleur PCR (Biosystems, USA) was used to perform amplification reactions. The amplification parameters for the ces cluster were as follows: 5 min at 95 °C, 30 cycles of 15 s at 95 °C, 30 s at 58 °C, and 30 s at 72 °C, and an 8-min final extension at 72 °C. Two minutes at 94 °C, ten cycles of 10 s at 94 °C, 30 s at 58 °C, and two min at 68 °C were the amplification conditions for hblB. Twenty cycles of 10 s at 94 °C, 30 s at 58 °C, and 2 min (plus an extra 20 s per cycle) at 68 °C were performed after these ten cycles, with a final extension at 68 °C lasting 7 min (Ehling-Schulz et al., 2004, 2005; Guinebretière et al., 2002). The amplification conditions for the other toxin genes (hblA, nheA, nheB, and bceT) were as follows: 4 min at 95 °C, 30 cycles of 30 s at 95 °C, 30 s at the corresponding annealing temperatures as indicated in Table 1, and 1 min at 72 °C, culminating in a final extension of 7 min at 72 °C. A negative control comprising the entire PCR mixture devoid of any DNA template was included in every run (Techer et al., 2014).
2.4 Antibiotic susceptibility assay
The disc diffusion technique was used to assess the susceptibility of B. cereus isolates to fifteen different antibiotics, including ciprofloxacin (5 μg), amikacin (30 μg), chloramphenicol (30 μg), novobiocin (30 μg), fusidic acid (10 μg/ml), streptomycin (10 μg), kanamycin (30 μg), ampicillin (10 μg), vancomycin (30 μg), oxacillin (1 μg), gentamicin (10 μg), nitrofuran (50 μg), erythromycin (15 μg), tetracycline (30 μg), and rifampicin (5 μg) (Oxoid, England). A 100 μl of B. cereus isolates freshly prepared at 0.5 McFarland were spread on the MHA surface and loaded with antibiotic discs. For 20–24 h, the plates were incubated at incubated at 30 °C. The inhibition zone was measured and interpreted according to guidelines established by the Clinical and Laboratory Standards Institute (CLSI) (CLSI, 2023).
2.5 Antibacterial activity of A. vulgaris extracts against B. cereus isolates
To evaluate the antibacterial activity of A. vulgaris leaf extracts, the six highly resistant B. cereus isolates were cultivated in MHB and incubated for 20 h at 37 °C. A 100 μl of bacterial suspension adjusted to a McFarland turbidity of 0.5 was spread on MHA surface plates. After inoculating the MHA with the freshly prepared bacterial isolates, wells of 6 mm in diameter were created using a sterile cork borer. Each well was filled with 100 μl of A. vulgaris extract at a concentration of 150 μg/ml, along with a gentamicin disc (10 μg/mL) as a positive control, and the plates were incubated for 2 h at 4 °C. Following a 24-h incubation period at 37 °C, the zones of inhibition on the plates were measured with (mm). The experiment was conducted in triplicate (Foda et al., 2022; Sharaf et al., 2021).
2.6 Minimum inhibitory concentration of methanolic A. vulgaris extract against B. cereus isolates
The MIC values of ciprofloxacin (HiMedia Laboratories Pvt. Ltd. India.) and highly active extract (methanolic A. vulgaris extract) were determined using microdilution assay in a 96 well plate. Muller Hinton broth medium was inoculated with a cell suspension of B. cereus isolates that had been calibrated to a concentration of (106 CFU/ml) and 200 μl of the inoculated medium was distributed in each well. Tested compounds (ciprofloxacin and methanolic A. vulgaris extract) were tested in a 2-fold serial dilution. Ciprofloxacin was tested at concentrations ranged from 0.1 to 10.0 μg/ml and methanolic A. vulgaris extract started with 0.0 to 1,000.0 μg/ml. The assay was performed according to the criteria of M7-A7. Wells containing negative control (medium + ciprofloxacin or methanolic A. vulgaris extract at the tested concentrations) were performed to determine the differences in optical density. The plates were incubated for 20 h at 30 °C and the absorbance was measured at 630 nm. MIC was defined as the lowest concentration of the ciprofloxacin or methanolic A. vulgaris extract which is able to inhibit the visible growth of B. cereus isolates (CLSI, 2023; El-Sherbiny et al., 2024).
2.7 Antibiofilm activity of methanolic A. vulgaris leaves extract
The efficacy of the methanolic extract of A. vulgaris leaves in preventing the formation of biofilms by B. cereus isolates was quantitatively assessed using the microplate assay. The B. cereus isolates were cultivated on MHB for 20 h. A 100 μl of a bacterial suspension adjusted to 0.5 McFarland turbidity was added to each well. The wells were filled with 100 microliters of methanolic extract of A. vulgaris leaves at three different concentrations (1/8, ¼, and ½ MIC). The experiment included wells with control of growth media without inoculum, methanolic extract, and growth media; wells containing growth media and bacterial suspension (untreated); and incubation at 37 °C for 24 h. The optical density (OD) was measured at 630 nm. The following formula was used to determine the percentage of biofilm inhibition: % inhibition = [(OD negative control – OD medium control) – (OD test – OD A. vulgaris control)]/(OD medium control – OD negative control) × 100 (Fareid et al., 2025). Three duplicates of the experiment were conducted, and the mean ± standard deviation was used to report the results.
2.8 Effects of methanolic A. vulgaris extract on expression of toxigenic and emetic genes in B. cereus isolates
A suspension of B. cereus isolates grown on MHB medium was prepared at a 0.5 McFarland concentration and then subjected to treatment with half the MIC of methanolic A. vulgaris extract, while untreated bacterial strains were used as a control. The cultures were incubated at 37 °C for 24 h. The expression levels of the hblA, hblB, nheA, nheB, bceT, and ces genes were analyzed using qRT-PCR, with the primer sequences provided in Table 1. cDNA synthesis was performed using the AMV reverse transcriptase enzyme (Roche, Basel, Switzerland) at a concentration of 25 units/L, along with transcriptase. To avoid the formation of secondary structures, the RNA extracted in the previous step was heated to 65 °C for 3 min. Reverse transcription (RT) was conducted at 42 °C for 60 min, utilizing 2 μL of random primer and 2 × AMV reverse transcriptase enzymes, followed by incubation and inactivation of the AMV enzyme at 99 °C for 5 min. Gene expression quantification was executed using the 2−ΔΔCT method (Guinebretière et al., 2002; Techer et al., 2014; Fareid et al., 2025).
2.9 Antioxidant efficacy of methanolic A. vulgaris extract
The antioxidant properties of methanolic A. vulgaris extract were assessed through two assays as follows:
2.9.1 DPPH assay
The antioxidant efficacy of methanolic A. vulgaris extract was evaluated through the DPPH radical scavenging method, as outlined in the study conducted by Shehata et al. (2024). The extract was analyzed at various concentrations: 1,000, 500, 250, 125, 62.5, 31.25, 15.62, and 7.81 μg/mL. A 0.1 mmol/L ethanol solution of DPPH was introduced to 5 mL of the sample, which was then mixed thoroughly. As a standard control, ascorbic acid was incorporated into experimental design. The mixture was allowed to rest for 20 min at 27 °C, after which the absorbance was measured at 517 nm. The IC50 values for both ascorbic acid and A. vulgaris extract were calculated, indicating the concentration required to achieve a 50% reduction in the initial DPPH concentration. The antioxidant capacity of methanolic A. vulgaris extract was assessed using the specified equation. To evaluate the DPPH scavenging activity, the following formula was applied: (Absorbance of ascorbic acid control – Absorbance of A. vulgaris extract)/Absorbance of ascorbic acid control × 100%. This experiment was performed in triplicate, and the results were reported as the mean value ± standard deviation.
2.9.2 ABTS assay
The antioxidant activity of methanolic A. vulgaris extract were analyzed through the ABTS [2,2′-azino-bis (3-ethylbenzothiazoline-6-sulfonic acid)] radical decolorization technique, which was slightly modified from the methodology presented by Elbestawy et al. (2023). The concentrations of methanolic A. vulgaris extract and ascorbic acid used in this research were 1,000, 500, 500, 500, 250, 125, 62.5, 31.25, 15.62, and 7.81 μg/mL. An ABTS radical was formed by combining a 7 mmol/L ABTS solution with 2.4 mmol/L potassium persulfate in a dark environment for 12–16 h at 25 °C. Before the reaction began, this solution was diluted in ethanol at a 1:89 (V/V) ratio and allowed to stabilize at 30 °C, with its absorbance recorded at 734 nm. The antioxidant activity of both the standard and A. vulgaris extract were determined as ABTS scavenging activity (%) through the application of the following equation:
The experiment was carried out in triplicate, and the results were expressed as mean values ± standard deviation.
2.9.2.1 Cytotoxicity study of methanolic A. vulgaris extract
The cytotoxic effects of methanolic A. vulgaris extract were assessed through the MTT assay as described by Shehata et al. (2024). The cell lines utilized, which included Vero cells and HFB4, were sourced from ATCC in Rockville. The existing adherent culture medium was replaced with a fresh medium containing varying concentrations of A. vulgaris extract, specifically ranging from 1,000 to 31.25 μg/mL, and the cells were incubated at 37 °C for a period of 24 h. Following the incubation period, the cells underwent three washes with either fresh medium or cold phosphate-buffered saline (PBS) and were subsequently treated with 0.5 mg/mL MTT solution for a time frame of 2–5 h. Upon completion of the MTT treatment, the solution was discarded, and 200 μL of dimethyl sulfoxide (DMSO) was introduced to each well to facilitate the dissolution of the formazan crystals. The optical density (OD) was then recorded at 570 nm, and the percentages of cell viability and cell death were computed using the relevant formulas:
Three repetitions of the experiment were performed, and the results were reported as mean ± standard deviation.
2.10 Characterization of the methanolic A. vulgaris extract by GC-MS
The methanolic extract of A. vulgaris was subjected to analysis and identification through GC-MS spectroscopy, following the protocol established by El-Sherbiny et al. (2022), with minor modifications. The extract was prepared using analytical grade methanol. The GC-MS analysis was performed utilizing a Thermo Scientific trace GC1310-ISQ mass spectrometer (Austin, Texas, USA), which was equipped with a direct capillary column measuring 25 mm in length, 0.25 μm in thickness, and possessing an internal diameter of 30 mm. A 1 μl sample was injected at a temperature of 250 °C, with a helium to sample ratio of 1:30 acting as the carrier gas. The oven temperature was held at 50 °C for 5 min before being increased to 230 °C at a rate of 5 °C per minute, where it was maintained for an additional 2 min. The mass spectrometer functioned in electron ionization (EI) mode at 200 °C and 70 eV, scanning a range from 40 to 1,000 m/z. The resulting spectra were compared against those of compounds cataloged in the NIST 11 and WILEY 09 libraries (Wiley, New York, NY, USA).
2.11 Characterization of methanolic A. vulgaris extract by HPLC
2.11.1 HPLC sample preparation
The methanolic A. vulgaris extract was evaluated using a validated HPLC method. Ten milliliters of 50% methanol were used to dissolve 100 milligrams of the extract, which had been precisely measured. After passing through a nylon membrane filter with a pore size of 0.2 μm, the solution was put through a triple analysis.
2.11.2 HPLC equipment and chromatographic parameters
The extract of A. vulgaris was introduced into a HPLC system (Shimadzu SPD-10 A, Kyoto, Japan), which comprised a SIL-10AD auto-injector, an SPD-10AV UV-Vis detector (280 nm), a DGU-10 A degasser, and an LC-10AD pump. For the separation process, a Shim-pack CLC-ODS (C-18) (2 cm, 4.6 mm, 5 μm) sourced from Cheshire, UK was utilized, in conjunction with a C18 guard column. The elution was executed using a gradient solvent system consisting of 1% acetic acid (solvent A) and acetonitrile (solvent B) as the mobile phases. The gradient was defined as A (H2O: AA 94:6, pH = 2.27), B (ACN 100%), with the intervals of 0–15 min indicating 15% B, 15–30 min indicating 45% B, and 30–45 min indicating 100% B. The flow rate was maintained at one milliliter per minute at room temperature. The peak width for each compound's HPLC analysis was taken into account (El-Sherbiny et al., 2024).
2.12 Statistical analysis
The experiments were conducted in triplicate, and the mean ± standard deviation was used to present the results. To compare the experimental and control groups, a two-way ANOVA was used. To identify statistically significant differences (p-value < 0.05), statistical analyses were performed using GraphPad Prism Software version 8.0 (GraphPad Software, Inc., La Jolla, CA, USA).
3 Results
3.1 Prevalence of genes encoding enterotoxins and emetic toxins among B. cereus isolates
A total of 58 Bacillus cereus isolates from various sample sources were analyzed using PCR to detect the presence of five diarrheal toxin-encoding genes hblA, hblB, nheA, nheB, and bceT and one emetic toxin-encoding gene, ces. The results showed that the B. cereus isolates possessed the nhe and hbl gene complexes at frequencies of 43.09% and 29.31%, respectively. Among the enterotoxin genes, nheA and nheB were detected in 20.68% and 22.41% of the isolates, respectively, while hblA and hblB were present in 8.62% and 20.68% of the isolates, respectively. The nhe gene complex was the most frequently detected, with both nheA and nheB present in 31.03% (18/58) of the isolates. In comparison, both hblA and hblB were found together in only 6.89% (4/58) of the isolates. Additionally, the bceT and ces genes were identified in 29.31% and 15.51% of the isolates, respectively, as summarized in Table 2.
3.2 Antimicrobial susceptibility of B. cereus isolates
The sensitivity of Bacillus cereus isolates to fifteen different antibiotics was evaluated using the disc diffusion method. The results showed that the isolates exhibited high sensitivity to rifampicin (96.54%), ciprofloxacin (91.37%), and fusidic acid (87.92%). In contrast, most isolates demonstrated resistance to ampicillin (86.20%), novobiocin (65.51%), and oxacillin (62.06%), as shown in Table 3. Multidrug resistance (MDR) was detected in 24.13% (14/58) of the B. cereus isolates.
3.3 Antibacterial activity of A. vulgaris extracts against B. cereus isolates
The A. vulgaris extracts demonstrated considerable antibacterial activity against various B. cereus isolates. The results showed that the aqueous extract of A. vulgaris produced inhibition zones ranging from 10.05 ± 0.41 mm to 15.06 ± 0.23 mm, the ethyl acetate extract from 10.07 ± 0.13 mm to 23.12 ± 0.40 mm, the methanol extract from 19.20 ± 0.25 mm to 27.10 ± 0.13 mm, and the chloroform extract from 11.30 ± 0.20 mm to 23.00 ± 0.17 mm. In comparison, gentamicin, used as a positive control, showed no activity against the isolates. Among all extracts, the methanolic extract exhibited the highest antibacterial activity, as shown in Table 4 and Figure 1.
Figure 1. Antibacterial activity of A. vulgaris leaves extracts against multidrug B. cereus isolates (1) water extract (2) ethyl acetate extract, (3) methanol extract, (4) chloroform extract and gentamicin as a positive control.
3.4 MIC of methanolic of A. vulgaris extract against MDR B. cereus
Due to the methanolic extract of A. vulgaris exhibiting higher antibacterial activity compared to the other solvent extracts, it was selected for minimum inhibitory concentration (MIC) assessment. The findings indicated that the methanolic A. vulgaris extract exhibited MIC values ranging from 62.5 to 250 μg/ml against multidrug-resistant (MDR) B. cereus isolates, compared to ciprofloxacin, which showed MIC values ranging from 2.0 to 10.0 μg/ml, as detailed in Table 5 and Figure 2.
3.5. Antibiofilm activity of methanolic A. vulgaris extract against MDR B. cereus
The antibiofilm efficacy of the methanolic A. vulgaris leaf extract demonstrated significant anti-biofilm activity against MDR B. cereus isolates at concentrations of 1/8, 1/4, and 1/2 MIC. Notably, biofilm formation by isolates 19, 24, 37, and 52 was completely inhibited at the 1/2 MIC concentration, as shown in Figure 3.

Figure 3. Antibiofilm activity of methanolic A. vulgaris extract against MDR B. cereus isolates (***p ≤ 0.0001).
3.6 Effects of methanolic A. vulgaris extract on expression toxigenic and emetic genes in B. cereus isolates
The findings reveal that B. cereus strains treated with the methanolic A. vulgaris extract at half the MIC for an overnight period showed a significant reduction in the expression levels of the hblA, hblB, nheA, nheB, bceT, and ces genes, with a fold change ranging from −2.5 to −5.2 (***P < 0.0001) compared to the untreated control isolates. This result suggests that the methanolic A. vulgaris extract contributes to the downregulation of toxigenic genes, as illustrated in Figure 4.

Figure 4. qRT-PCR expression of toxigenic and emetic genes (hblA, hblB, nheA, nheB, bceT, and ces) in B. cereus treated with ½ A. vulgaris leaves methanolic extract and untreated (***p ≤ 0.0001).
3.7 Antioxidant activity methanolic A. vulgaris leaves extract
In this study, DPPH and ABTS assays were employed to evaluate the antioxidant potential of the methanolic A. vulgaris extract and its ability to scavenge free radicals. The DPPH assay revealed that the methanolic A. vulgaris extract exhibited an antioxidant capacity with an IC50 value of 12.7 μg/mL, compared to 8.9 μg/mL for ascorbic acid. Similarly, the ABTS assay yielded IC50 values of 14.2 μg/mL for the extract and 7.61 μg/mL for ascorbic acid, as shown in Figures 5A, B. These findings indicate that while the A. vulgaris extract possesses antioxidant activity, it is significantly less effective than ascorbic acid in scavenging free radicals.
3.8 Cytotoxic activity of methanolic A. vulgaris extract against Vero and HFB4 cells
The treatment of Vero and HFB4 cell lines with the methanolic A. vulgaris extract at various concentrations for 24 h resulted in minor morphological changes on the cell surface and within the cytoskeleton, which were observed in relation to cell viability compared to the control group. The MTT assay results also showed a significant reduction in cell viability starting at concentrations of 200 μg/mL and above. The IC50 values indicating the concentration required to inhibit 50% of cell viability were determined to be 236.5 ± 1.74 μg/mL for Vero cells and 524.7 ± 1.23 μg/mL for HFB4 cells, as illustrated in Figure 6. These results indicate that the methanolic A. vulgaris extract is safe at low concentrations.

Figure 6. Cytotoxicity effects of methanolic A. vulgaris leaves extract on Vero and HFB4 cells lines.
3.9 Identification of methanolic A. vulgaris extract components by HPLC and GC-MS analysis
GC-MS analysis of the methanolic A. vulgaris extract identified fifteen compounds, with dopamine N, N-dimethyl-dimethyl ether (40.31%) being the most abundant, followed by n-hexadecanoic acid (16.57%) and 5,11,17,23-tetrakis (15.30%), as shown in Figure 7 and Table 6. HPLC analysis using a UV-Vis diode array detector (DAD) was employed to identify and quantify phenolic compounds and flavonoids present in the methanolic extract of A. vulgaris leaves. This analysis was based on peak area percentage and retention time (RT), as presented in Table 7. Among the detected polyphenolic compounds, the major constituents were chlorogenic acid (39.13% at RT 4.51 min), gallic acid (11.62% at 3.14 min), caffeic acid (1.23% at 5.07 min), coumaric acid (8.40% at 8.91 min), ferulic acid (1.22% at 9.50 min), and cinnamic acid (0.18% at 13.14 min).For flavonoids, quercetin showed a prominent peak at RT 2.72 min with a relative abundance of 15.13%, followed by luteolin (17.45% at 3.94 min), pinocembrin (7.24% at 0.85 min), rhamnetin (4.34% at 6.75 min), chrysin (2.31% at 10.21 min), and hesperidin (0.31% at 14.59 min).
4 Discussion
This study emphasized the toxigenic potential of B. cereus strains isolated from various food samples. The results underscore the importance of monitoring and controlling these pathogens within the food supply to protect public health and prevent foodborne illnesses. The findings demonstrated that B. cereus isolates exhibit multi-toxigenicity, harboring at least one gene from both the NHE and HBL complexes, in addition to the bceT and ces genes. These observations are consistent with previous findings reported by Gdoura-Ben Amor et al. (2019). Furthermore, Tewari et al. (2015) found that 55.2% and 89.7% of B. cereus strains tested positive for at least one of the HBL and NHE genetic determinants, respectively. Our analysis also showed that genes associated with the HBL complex were present at a lower frequency than those of the NHE complex, consistent with earlier studies by Tewari et al. (2015) and Castiaux et al. (2016), which reported that HBL-related genes are less prevalent than NHE-related ones. The occurrence of hblA and hblB genes aligns with findings by Ceuppens et al. (2011), who observed that 84–100% of B. cereus group strains carried nhe genes, while hbl genes were detected in 29–92% of the isolates they examined. In our study, both genes of the NHE complex were detected in 31.03% (18/58) of the isolates, while 6.89% (4/58) carried the complete HBL gene complex. These results disagree with those reported by Ngamwongsatit et al. (2008), who found that none of the 411 B. cereus strains evaluated harbored one or more genes from the HBL or NHE complexes. This may be attributed to the inability to detect all genes by PCR in most isolates, as well as the presence of polymorphisms in the sequences of the HBL and NHE complex genes, rather than their complete absence (Guinebretiere et al., 2006). In this study, the bceT and ces genes were detected in 29.30% and 15.51% of B. cereus isolates, respectively. The occurrence of emetic intoxication genes is often associated with starchy foods such as rice, noodles, pasta, and mashed potatoes (Agata et al., 2002; Naranjo et al., 2011). In addition, consistent with our findings, López et al. (2015) and Messelhäusser et al. (2014) reported the identification of emetic B. cereus group strains in cooked chicken, as well as in foods such as soups, sauces, and mixed or buffet meals. However, none of the B. cereus group strains isolated from spices contained the emetic toxin gene (ces) in studies conducted by Hariram and Labbé (2015) and Fogele et al. (2018).
Foodborne pathogens pose a significant global challenge, serving as reservoirs of infection and contributing to the development of antimicrobial resistance. Our investigation revealed that B. cereus isolates exhibited varying levels of susceptibility to the antimicrobial agents tested. The majority of B. cereus isolates were resistant to ampicillin, consistent with previous studies reporting notable resistance of this group to β-lactam antibiotics (Gdoura-Ben Amor et al., 2019; Lee et al., 2012; Park et al., 2009). This may be attributed to the strains' ability to produce β-lactamases-enzymes that play a crucial role in the degradation of antibiotics (Park et al., 2009). In the context of the B. cereus group, β-lactamase production can confer resistance even to third-generation cephalosporins (Özcelik and Citak, 2009). In our study, 65.5% of the strains were resistant to novobiocin. In contrast, Aklilu et al. (2016) reported that all B. cereus group isolates they tested were resistant to novobiocin. In our study, more than 96%, 91%, and 87% of B. cereus isolates were sensitive to rifampicin, ciprofloxacin, and fusidic acid, respectively. These findings are consistent with results reported by Gdoura-Ben Amor et al. (2019) who demonstrated that all B. cereus isolates were fully sensitive to rifampicin, chloramphenicol, ciprofloxacin, and gentamicin. Furthermore, Banerjee et al. (2011) reported that 100% of B. cereus isolates were sensitive to ciprofloxacin in patient samples, and other studies have produced similar results when evaluating sensitivity to ciprofloxacin in food samples (Aklilu et al., 2016; Oladipo and Adejumobi, 2010; Jensen et al., 2001). In the current study, MDR was identified in 24.13% (14/58) of the B. cereus isolates. In the previous study, an analysis of the susceptibility B. cereus isolates revealed that only two strains were non-resistant to 15 antibiotics, while the majority strains demonstrated resistance to three or more antibiotics. Additionally, certain reports have indicated the presence of carbapenem-resistant B. cereus bacteremia, and some in vitro investigations have revealed that B. cereus genetically harbors metallo-beta lactamase activity, which contributes to its antibiotic resistance profile. This alarming trend underscores the importance of continuous monitoring and the development of new therapeutic strategies to combat infections caused by this pathogen (Ikeda et al., 2015; Cha et al., 2023).
Natural substances obtained from plants have long been used in the pharmaceutical, food, and cosmetics industries, with documentation found in multiple nations. Ancient cultures relied on these products for both nutritional and therapeutic applications. In the past few decades, there has been a marked surge in researchers' interest in analyzing the specifics of their compositions and investigating their potential applications in diverse fields (El-Sherbiny and Elbestawy, 2022). We utilize the natural compounds available to us to tackle the increasing prevalence of diseases like cancer, diabetes, obesity, heart attacks, microbial infections, accelerated skin aging, and other new health challenges (El-Sherbiny et al., 2024). The application of natural materials offers notable benefits over medications that are derived from synthetic sources. Because of their limited side effects, this strategy is often viewed as the most advantageous when assessing the toxicological and pharmacological properties of these compounds in comparison to those from chemical origins. A broad spectrum of pharmacological effects has been discovered in extracts of natural products, which include antibacterial, antioxidant, antidiabetic, anti-inflammatory, cardio-protective, neuroprotective, immunomodulatory, antiparasitic, and antiviral functions. Different plant parts, such as seeds, roots, stems, bark, leaves, flowers, and fruits, each have unique phytochemical compositions and potential medicinal advantages (Elbestawy et al., 2023; El-Sherbiny et al., 2022). In this study, extracts derived from A. vulgaris leaves exhibited notable antibacterial activity against MDR B. cereus isolates, with the methanolic extract being the most active, showing MIC values ranging from 62.5 to 250 μg/mL. Recent investigations have revealed that A. vulgaris, a key therapeutic plant species in the Artemisia genus, possesses a variety of properties, including antioxidant, hypolipidemic, antispasmodic, analgesic, estrogenic, cytotoxic, antibacterial, antifungal, hypotensive, and broncho-lytic activities (Singh et al., 2023; Bordean et al., 2023). This suggests the potential of A. vulgaris as a natural antimicrobial agent for combating foodborne B. cereus. Furthermore, several investigations have documented the antibacterial effects of A. vulgaris extract on a wide range of bacterial species, including Acinetobacter calcoaceticus, B. cereus, B. subtilis, Enterobacter faecalis, Escherichia coli, Klebsiella pneumoniae, Proteus vulgaris, Salmonella typhimurium, Serratia marcescens, Staphylococcus aureus, and Escherichia coli. This implies that A. vulgaris extract could be an important resource in the formulation of new antibacterial treatments, especially given the rising challenge of antibiotic resistance (Oyedemi and Coopoosamy, 2015; Gou et al., 2023).
Our findings showed that the methanolic extract from A. vulgaris exhibited a partial inhibitory effect on biofilm formation by B. cereus isolates at concentrations of 1/8 and ¼ MIC, while at ½ MIC, it completely inhibited biofilm formation in some B. cereus isolates. These results are consistent with previous studies reporting the effectiveness of plant extracts in suppressing biofilm formation among various bacterial species (Shehata et al., 2024; El-Sherbiny et al., 2022). Furthermore, essential oils from Artemisia dracunculus have been shown to effectively inhibit biofilm formation in S. Typhimurium (P < 0.001) at concentrations of ½ and ¼ MIC (Mohammadi Pelarti et al., 2021). In the current study, PCR was used to investigate the effect of methanolic A. vulgaris extract on the expression of toxigenic and emetic genes in B. cereus isolates. The results indicate that A. vulgaris extract downregulated several diarrheal toxin-encoding genes (hblA, hblB, nheA, nheB, bceT, and ces) by −2.5- to −5.2-fold (P < 0.0001) at ½ MIC. Similarly, a previous study by Mohammadi Pelarti et al. (2021). demonstrated that essential oils extracted from Artemisia dracunculus significantly downregulated the expression of quorum sensing–related genes luxS and pfs by −4.18- and −3.12-fold, respectively, in S. Typhimurium, and the hld gene in S. aureus by −5.35-fold at ½ MIC.
Our investigation revealed that the methanolic extract of A. vulgaris exhibits significant antioxidant activity, as confirmed by both DPPH and ABTS assays. Antioxidants are known to eliminate reactive oxygen species (ROS), reduce oxidative stress, protect cells and tissues from damage, lower the risk of gout, and improve overall patient health (El-Sherbiny et al., 2024). Trinh et al. (2024) reported that the ethyl acetate fraction of Artemisia extract contained the highest concentrations of total polyphenols and flavonoids. This fraction also demonstrated strong antioxidant activity across several assays, including DPPH, ABTS, reducing power, and hydrogen peroxide (H2O2) scavenging. Additionally, the antioxidant properties of A. vulgaris were investigated by Sharmila and Aadma (2014), who used a methanolic extract in chick embryos exposed to oxidative stress. Their research showed that the presence of A. vulgaris enhanced the antioxidant activity of primary cells under such conditions. Another study by Haniya and Padma (2014) found that the methanolic extract exhibited the most effective free radical scavenging activity against agents such as DPPH, ABTS, hydrogen peroxide, superoxide, hydroxyl radicals, and nitric oxide. These findings further validate the strong antioxidant potential of A. vulgaris leaf extract. Our investigation demonstrated that the methanolic extract of A. vulgaris exhibits minimal cytotoxic effects on Vero and HFB4 cell lines, with IC50 values of 236.5 ± 1.74 μg/mL for Vero cells and 524.7 ± 1.23 μg/mL for HFB4 cells. These findings align with the results reported by Jakovljević et al. (2023), who observed minimal cytotoxicity of A. vulgaris acetone extract in SW-480 cells, in contrast to a significant cytotoxic effect from A. alba extract (IC50 values of 240.12 ± 25.49 μg/mL for A. vulgaris vs. 3.89 ± 1.47 μg/mL for A. alba). According to current literature, the concentration of chemical constituents in Artemisia extracts can vary depending on harvest time, geographic location, soil conditions, and genetic factors (Mohammadi Pelarti et al., 2021). The predominant compound identified in the methanolic leaf extract of A. vulgaris was dopamine N, N-dimethyl-dimethyl ether (40.31%), followed by n-hexadecanoic acid (16.57%). Earlier studies by Hammad et al. (2024) also identified dopamine N,N-dimethyl-dimethyl ether as a major plant-derived compound. Antibacterial assessments revealed significant activity against Staphylococcus aureus and Pseudomonas aeruginosa, even at low concentrations. Medicinal plants, including Artemisia species, have long been used to treat high fevers caused by malaria in countries such as Ghana, Mali, Nigeria, and Zambia. It has been established that Artemisia species contain essential oils capable of inhibiting the growth of various pathogenic bacteria, including Staphylococcus aureus and Staphylococcus epidermidis (Mohammed et al., 2022). In this study, HPLC analysis of A. vulgaris indicated a high content of chlorogenic acid, luteolin, and quercitrin. These results are consistent with previous literature (Melguizo-Melguizo et al., 2014; Neagu et al., 2023). The phenolic and flavonoid compounds in A. vulgaris extracts possess notable antidiabetic, anti-inflammatory, antioxidant, and antibacterial properties (Medeiros et al., 2022; Rasul et al., 2013; Mani and Natesan, 2018; Ji et al., 2024; Tewari et al., 2015).
5 Conclusion
This study highlights the toxigenic potential of B. cereus group strains isolated from various food samples. The findings indicate that these isolates possess significant toxigenic capabilities and antibiotic resistance, which may pose a serious public health concern. To reduce the risk of foodborne illness, it is essential to implement strict food safety protocols and increase public awareness regarding proper food handling practices. Additionally, further research is needed to explore effective strategies for controlling and preventing the spread of these resistant strains in food products. The results also demonstrated the ability of methanolic A. vulgaris extract to inhibit B. cereus isolates, suppress biofilm formation, and downregulate virulence gene expression. This suggests that A. vulgaris extract represents a promising alternative approach for combating B. cereus. Future studies may investigate the synergistic effects of A. vulgaris extract in various food matrices to optimize its protective potential.
Data availability statement
All data generated or analyzed during this study are included in the article.
Author contributions
MF: Conceptualization, Data curation, Formal analysis, Funding acquisition, Investigation, Methodology, Project administration, Resources, Software, Supervision, Validation, Visualization, Writing – original draft, Writing – review & editing. GE-S: Conceptualization, Data curation, Formal analysis, Funding acquisition, Investigation, Methodology, Project administration, Resources, Software, Supervision, Validation, Visualization, Writing – original draft, Writing – review & editing. NME: Writing – original draft, Writing – review & editing. NEE: Writing – original draft, Writing – review & editing. MO: Writing – original draft, Writing – review & editing. MS: Writing – original draft, Writing – review & editing. MA-E: Writing – original draft, Writing – review & editing. DE: Conceptualization, Writing – original draft, Investigation, Methodology, Visualization. FH: Writing – original draft, Writing – review & editing.
Funding
The author(s) declare that financial support was received for the research and/or publication of this article. This research has been funded by Scientific Research Deanship at University of Ha'il - Saudi Arabia through project number: RG-24 115.
Acknowledgments
The authors would like to thank the Scientific Research Deanship at University of Ha'il - Saudi Arabia.
Conflict of interest
The authors declare that the research was conducted in the absence of any commercial or financial relationships that could be construed as a potential conflict of interest.
Generative AI statement
The author(s) declare that no Gen AI was used in the creation of this manuscript.
Any alternative text (alt text) provided alongside figures in this article has been generated by Frontiers with the support of artificial intelligence and reasonable efforts have been made to ensure accuracy, including review by the authors wherever possible. If you identify any issues, please contact us.
Publisher's note
All claims expressed in this article are solely those of the authors and do not necessarily represent those of their affiliated organizations, or those of the publisher, the editors and the reviewers. Any product that may be evaluated in this article, or claim that may be made by its manufacturer, is not guaranteed or endorsed by the publisher.
References
Agata, N., Ohta, M., and Yokoyama, K. (2002). Production of Bacillus cereus emetic toxin (cereulide) in various foods. Int. J. Food Microbiol. 73, 23–27. doi: 10.1016/S0168-1605(01)00692-4
Aklilu, E., Tukimin, E., Daud, N. H. A., and Kyaw, T. (2016). Enterotoxigenic Bacillus cereus from cooked chicken meat: a potential public health hazard. Malays. J. Microbiol. 12, 112–115. doi: 10.21161/mjm.70215
Banerjee, M., Nair, G. B., and Ramamurthy, T. (2011). Phenotypic and genetic characterization of Bacillus cereus isolated from the acute diarrhoeal patients. Indian J. Med. Res. 133, 88–95.
Bennett, S. D., Walsh, K. A., and Gould, H. A. (2013). Foodborne disease outbreaks caused by Bacillus cereus, Clostridium perfringens, and Staphylococcus aureus-United States, 1998-2008. Clin. Infect. Dis. 57, 425–433. doi: 10.1093/cid/cit244
Bordean, M. E., Ungur, R. A., Toc, D. A., Borda, I. M., Marţiş, G. S., Pop, C. R., et al. (2023). Antibacterial and phytochemical screening of artemisia species. Antioxidants 12:596. doi: 10.3390/antiox12030596
Bottone, E. J. (2010). Bacillus cereus, a volatile human pathogen. Clin. Microbiol. Rev. 23, 382–398. doi: 10.1128/CMR.00073-09
Bressuire-Isoard, C., Broussolle, V., and Carlin, F. (2018). Sporulation environment influences spore properties in Bacillus: evidence and insights on underlying molecular and physiological mechanisms. FEMS Microbiol. Rev. 42, 614–626. doi: 10.1093/femsre/fuy021
Caro-Astorga, J., Álvarez-Mena, A., Hierrezuelo, J., Guadix, J. A., Heredia-Ponce, Z., Arboleda-Estudillo, Y., et al. (2020). Two genomic regions encoding exopolysaccharide production systems have complementary functions in B. cereus multicellularity and host interaction. Sci. Rep. 10:1000. doi: 10.1038/s41598-020-57970-3
Castiaux, V., Laloux, L., Schneider, Y. J., and Mahillon, J. (2016). Screening of cytotoxic B. cereus on differentiated caco-2 cells and in co-culture with mucus secreting (HT29-MTX). Cells Toxins. 8, 1–20. doi: 10.3390/toxins8110320
Castiaux, V., Liu, X., Delbrassinne, L., and Mahillon, J. (2015). Is cytotoxin K from Bacillus cereus a bona fide enterotoxin? Int. J. Food Microbiol. 211, 79–85. doi: 10.1016/j.ijfoodmicro.2015.06.020
Ceuppens, S., Rajkovic, A., Hamelink, S., Van de Wiele, T., Boon, N., and Uyttendaele, M. (2012). Enterotoxin production by Bacillus cereus under gastrointestinal conditions and their immunological detection by commercially available kits. Foodborne Pathog. Dis. 9, 1130–1136. doi: 10.1089/fpd.2012.1230
Ceuppens, S., Rajkovic, A., Heyndrickx, M., Tsilia, V., Van De Wiele, T., Boon, N., et al. (2011). Regulation of toxin production by Bacillus cereus and its food safety implications. Crit. Rev. Microbiol. 1, 1–26. doi: 10.3109/1040841X.2011.558832
Cha, X., Lin, Y., Brennan, C., Cao, J., and Shang, Y. (2023). Antibiotic Resistance of Bacillus cereus in Plant Foods and Edible Wild Mushrooms in a Province. Microorganisms. 11, 2948. doi: 10.3390/microorganisms11122948
Choma, C., and Granum, P. E. (2002). The enterotoxin T (BceT) from Bacillus cereus can probably not contribute to food poisoning. FEMS Microbiol. Lett. 217, 115–119. doi: 10.1111/j.1574-6968.2002.tb11464.x
CLSI (2023). Performance Standards for Antimicrobial Susceptibility Testing, 31st Edn. CLSIsupplement M100,6. Wayne, PA: Clinical and Laboratory Standards Institute.
Duport, C., Jobin, M., and Schmitt, P. (2016). Adaptation in Bacillus cereus: from stress to disease. Front. Microbiol. 7:1550. doi: 10.3389/fmicb.2016.01550
Ehling-Schulz, M., Fricker, M., and Scherer, S. (2004). Identification of emetic toxin producing Bacillus cereus strains by a novel molecular assay. FEMS Microbiol. Lett. 232, 189–195. doi: 10.1016/S0378-1097(04)00066-7
Ehling-Schulz, M., Vukov, N., Schulz, A., Shaheen, R., Andersson, M., Märtlbauer, E., et al. (2005). Identification and partial characterization of the nonribosomal peptide synthetase gene responsible for cereulide production in emetic Bacillus cereus. Appl. Environ. Microbiol. 71, 105–113. doi: 10.1128/AEM.71.1.105-113.2005
Elbestawy, M. K. M., El-Sherbiny, G. M., and Moghannem, S. A. (2023). Antibacterial, antibiofilm and anti-inflammatory activities of eugenol clove essential oil against resistant Helicobacter pylori. Molecules 28:2448. doi: 10.3390/molecules28062448
El-Sherbiny, G. M., Alluqmani, A. J., Elsehemy, I. A., and Kalaba, M. H. (2024). Antibacterial, antioxidant, cytotoxicity, and phytochemical screening of Moringa oleifera leaves. Sci. Rep. 14:30485. doi: 10.1038/s41598-024-80700-y
El-Sherbiny, G. M., and Elbestawy, M. K. M. (2022). A review–plant essential oils active against Helicobacter Pylori. J. Essent. Oil Res. 34, 203–215. doi: 10.1080/10412905.2022.2025464
El-Sherbiny, G. M., Gazelly, A. M., Sharaf, M. H., Moghannemm, S. A., Shehata, M., and Ismail MK, A. (2022). El-Hawary exploitation of the antibacterial, antibiofilm and antioxidant activities of Salvadora persica (Miswak) extract. A.S J. Bioresour. Bioprod. 8, 59–65. doi: 10.1016/j.jobab.2022.11.006
Enosi Tuipulotu, D., Mathur, A., Ngo, C., and Man, S. M. (2021). Bacillus cereus: epidemiology, virulence factors, and host-pathogen interactions. Trends Microbiol. 29, 458–471. doi: 10.1016/j.tim.2020.09.003
Fareid, M. A., El-Sherbiny, G. M., Askar, A. A., Abdelaziz, A. M., Hegazy, A. M., Ab Aziz, R., et al. (2025). Impeding biofilm-forming mediated methicillin-resistant Staphylococcus aureus and virulence genes using a biosynthesized silver nanoparticles–antibiotic combination. Biomolecules 15:266. doi: 10.3390/biom15020266
Foda, A. M., Kalaba, M. H., El-Sherbiny, G. M., Saad, A. M., and El-Fakharany, E. M. (2022). Antibacterial activity of essential oils for combating colistin-resistant bacteria. Expert Rev. Anti-infect. Ther. 20, 1351–1364. doi: 10.1080/14787210.2022.2101997
Fogele, B., Granta, R., Valcina, O., and Bērzinš, A. (2018). Occurrence and diversity of Bacillus cereus and moulds in spices and herbs. Food Control 83, 69–74. doi: 10.1016/j.foodcont.2017.05.038
Gdoura-Ben Amor, M., Jan, S., Baron, F., Grosset, N., Culot, A., Gdoura, R., et al. (2019). Toxigenic potential and antimicrobial susceptibility of Bacillus cereus group bacteria isolated from Tunisian foodstuffs. BMC Microbiol. 19:196. doi: 10.1186/s12866-019-1571-y
Gou, J., Lu, Y., Xie, M., Tang, X., Chen, L., Zhao, J., et al. (2023). Antimicrobial activity in Asterceae: the selected genera characterization and against multidrug resistance bacteria. Heliyon 9:e14985. doi: 10.1016/j.heliyon.2023.e14985
Guinebretière, M. H., Broussolle, V., and Nguyen-The, C. (2002). Enterotoxigenic profiles of food-poisoning and food-borne Bacillus cereus strains. J. Clin. Microbiol. 40, 3053–3056. doi: 10.1128/JCM.40.8.3053-3056.2002
Guinebretiere, M. H., Fagerlund, A., Granum, P. E., and Nguyen-The, C. (2006). Rapid discrimination of cytK-1 and cytk-2 genes in Bacillus cereus strains by a novel duplex PCR system. FEMS Microbiol. Lett. 259, 74–80. doi: 10.1111/j.1574-6968.2006.00247.x
Hammad, A. A., Abdelgadir, A. A., Yassin, S., and Alzain, A. A. (2024). GC-MS, antibacterial and in silico studies of sudanese Acacia polyacantha Stem bark alcoholic extract. J. Exp. Pharmacol. 16, 365–376. doi: 10.2147/JEP.S480839
Haniya, A. K., and Padma, P. (2014). Phytochemical investigation of methanolic extract of Artemisia vulgaris L. leaves. IJPBS. 5, 184–195.
Hansen, B. M., Høiby, P. E., Jensen, G. B., and Hendriksen, N. B. (2003). The Bacillus cereus BceT enterotoxin sequence reappraised. FEMS Microbiol. Lett. 223, 21–24. doi: 10.1016/S0378-1097(03)00249-0
Hariram, U., and Labbé, R. (2015). Spore prevalence and toxigenicity of Bacillus cereus and Bacillus thuringiensis isolates from U.S. retail spices. J. Food Prot. 78, 590–596. doi: 10.4315/0362-028X.JFP-14-380
Hwang, J. Y., and Park, J. H. (2010). Survival and growth of Bacillus cereus group and presumptive Cronobacter spp. contaminated naturally in rehydrated Sunsik. Food Sci. Biotechnol. 19, 1683–1687. doi: 10.1007/s10068-010-0239-z
Ikeda, M., Yagihara, Y., Tatsuno, K., Okazaki, M., Okugawa, S., and Moriya, K. (2015). Clinical characteristics and antimicrobial susceptibility of Bacillus cereus blood stream infections. Ann. Clin. Microbiol. Antimicrob. 14:43. doi: 10.1186/s12941-015-0104-2
Ikram, S., Heikal, A., Finke, S., Hofgaard, A., Rehman, Y., Sabri, A. N., et al. (2019). Bacillus cereus biofilm formation on central venous catheters of hospitalised cardiac patients. Biofouling 35, 204–216. doi: 10.1080/08927014.2019.1586889
Jakovljević, M. R., Milutinović, M., Predrag Djurdjević, P., Todorović, Z., Stankovic, M., and Milošević-Djordjević, O. (2023). Cytotoxic and apoptotic activity of acetone and aqueous Artemisia vulgaris L. and Artemisia alba Turra extracts on colorectal cancer cells. Eur. J. Integr. Med. 57:102204. doi: 10.1016/j.eujim.2022.102204
Jensen, L. B., Baloda, S., Boye, M., and Aarestrup, F. M. (2001). Antimicrobial resistance among Pseudomonas spp. and the Bacillus cereus group isolated from Danish agricultural soil. Environ. Int. 26, 581–587. doi: 10.1016/S0160-4120(01)00045-9
Ji, Z., Deng, W., Chen, D., Liu, Z., Shen, Y., Dai, J., et al. (2024). Recent understanding of the mechanisms of the biological activities of hesperidin and hesperetin and their therapeutic effects on diseases. Heliyon 10:e26862. doi: 10.1016/j.heliyon.2024.e26862
Kailas, L., Terry, C., Abbott, N., Taylor, R., Mullin, N., Tzokov, S. B., et al. (2011). Surface architecture of endospores of the Bacillus cereus/anthracis/thuringiensis family at the subnanometer scale. Proc. Natl. Acad. Sci. U. S. A. 108, 16014–16019. doi: 10.1073/pnas.1109419108
Lee, N., Sun, J. M., Kwon, K. Y., Kim, H. J., Koo, M., and Chun, H. S. (2012). Genetic diversity, antimicrobial resistance, and toxigenic profiles of Bacillus cereus strains isolated from sunsik. J. Food Prot. 75, 225–230. doi: 10.4315/0362-028X.JFP-11-317
Li, T., Zou, Q., Chen, C., Li, Q., Luo, S., Li, Z., et al. (2023). A foodborne outbreak linked to Bacillus cereus at two middle schools in a rural area of Chongqing, China, 2021. PLoS ONE 18:e0293114. doi: 10.1371/journal.pone.0293114
López, A., Minnaard, J., Pérez, P., and Alippi, A. (2015). A case of intoxication due to a highly cytotoxic Bacillus cereus strain isolated from cooked chicken. Food Microbiol. 46, 195–199. doi: 10.1016/j.fm.2014.08.005
Mani, R., and Natesan, V. (2018). Chrysin: sources, beneficial pharmacological activities, and molecular mechanism of action. Phytochemistry 145, 187–196. doi: 10.1016/j.phytochem.2017.09.016
Medeiros, D. M., Lima, E. T. G., Silva, J. C., Medeiros, M. A., and Pinheiro, E. B. F. (2022). Rhamnetin: a review of its pharmacology and toxicity. J. Pharm. Pharmacol. 74, 793–799. doi: 10.1093/jpp/rgab163
Melguizo-Melguizo, D., Diaz-de-Cerio, E., Quirantes-Piné, R., Švarc-Gajic,', J, and Segura-Carretero, A. (2014). The potential of Artemisia vulgaris leaves as a source of antioxidant phenolic compounds. J. Func. Foods 10, 192–200. doi: 10.1016/j.jff.2014.05.019
Messelhäusser, U., Frenzel, E., Blöchinger, C., Zucker, R., Kämpf, P., and Ehling-Schulz, M. (2014). Emetic Bacillus cereus are more volatile than thought: recent foodborne outbreaks and prevalence studies in Bavaria (2007–2013). Biomed Res. Int. 2014:465603. doi: 10.1155/2014/465603
Mohammadi Pelarti, S., Karimi Zarehshuran, L., Babaeekhou, L., and Ghane, M. (2021). Antibacterial, anti-biofilm and anti-quorum sensing activities of Artemisia dracunculus essential oil (EO): a study against Salmonella enterica serovar Typhimurium and Staphylococcus aureus. Arch. Microbiol. 203, 1529–1537. doi: 10.1007/s00203-020-02138-w
Mohammed, S., Dekabo, A., and Hailu, T. (2022). Phytochemical analysis and anti-microbial activities of Artemisia spp. and rapid isolation methods of artemisinin. AMB Express 12:17. doi: 10.1186/s13568-022-01346-5
Naranjo, M., Denayer, S., Botteldoorn, N., Delbrassinne, L., Veys, J., Waegenaere, J., et al. (2011). Sudden death of a young adult associated with Bacillus cereus food poisoning. J. Clin. Microbiol. 49, 4379–4381. doi: 10.1128/JCM.05129-11
Neagu, E., Paun, G., Albu, C., Apreutesei, O. T., and Radu, G. L. (2023). In vitro assessment of the antidiabetic and anti-inflammatory potential of Artemisia absinthium, Artemisia vulgaris and Trigonella foenum-graecum extracts processed using membrane technologies. Molecules 28:7156. doi: 10.3390/molecules28207156
Ngamwongsatit, P., Buasri, W., Pianariyanon, P., Pulsrikarn, C., Ohba, M., Assavanig, A., et al. (2008). Broad distribution of enterotoxins genes (hblCDA, nheABC, cytK and entFM) among Bacillus thuringiensis and Bacillus cereus as shown by novel primers. Int. J. Food Microbiol. 121, 352–356. doi: 10.1016/j.ijfoodmicro.2007.11.013
Oladipo, I. C., and Adejumobi, O. D. (2010). Incidence of antibiotic resistance in some bacterial pathogens from street vended food in Ogbomoso, Nigeria. Park J Nutr. 9, 1061–1068. doi: 10.3923/pjn.2010.1061.1068
Oyedemi, S. O., and Coopoosamy, R. M. (2015). Preliminary studies on the antibacterial and antioxidative potentials of hydroalcoholic extract from the whole parts of Artemisia vulgaris L. Int. J. Pharmacol. 11, 561–569. doi: 10.3923/ijp.2015.561.569
Özcelik, B., and Citak, S. (2009). Evaluation of antibiotic resistance of Bacillus cereus isolates in ice-cream samples sold in Ancara. Turk. J. Pharm. Sci. 6, 231–238.
Pandey, B. P., Thapa, R., and Upreti, A. (2017). Chemical composition, antioxidant and antibacterial activities of essential oil and methanol extract of Artemisia vulgaris and Gaultheria fragrantissima collected from Nepal. Asian Pac. J. Trop. Med. 10, 952–959. doi: 10.1016/j.apjtm.2017.09.005
Park, Y. B., Kim, J. B., Shin, S. W., Kim, J. C., Cho, S. H., Lee, B. K., et al. (2009). Prevalence, genetic diversity, and antibiotic susceptibility of Bacillus cereus strains isolated from rice and cereals collected in Korea. J. Food Prot. 72, 612–617. doi: 10.4315/0362-028X-72.3.612
Rasul, A., Millimouno, F. M., Ali Eltayb, W., Ali, M., Li, J., and Li, X. (2013). Pinocembrin: a novel natural compound with versatile pharmacological and biological activities. Biomed Res. Int. 2013:379850. doi: 10.1155/2013/379850
Sharaf, M. H., El-Sherbiny, G. M., Moghannem, S. A., Abdelmonem, M., Elsehemy, I. A., Metwaly, A. M., et al. (2021). New combination approaches to combat methicillin-resistant Staphylococcus aureus (MRSA). Sci. Rep. 11, 1–16. doi: 10.1038/s41598-021-82550-4
Sharma, K. R. S. (2023). Phytochemical analysis and biological activities of Artemisia vulgaris grown in different altitudes of Nepal. Int. J. Food Propert. 26, 414–427. doi: 10.1080/10942912.2023.2166954
Sharmila, K., and Aadma, P. (2014). Effect of Artemisia vulgaris leaf extract on antioxidant status of primary chick embryo fibroblasts. IJPBS 5, 731–738.
Shehata, M. E., El-Sherbiny, G. M., Sharaf, M. H., Kalaba, M. H., and Shaban, A. S. (2024). Phytochemical analysis, antimicrobial, antioxidant, and cytotoxicity activities of Schinus molle (L.) extracts. Biomass Conv. Bioref. 15, 3753–3770. doi: 10.1007/s13399-024-05301-1
Singh, N. B., Devi, M. L., Biona, T., Sharma, N., Das, S., Chakravorty, J., et al. (2023). Phytochemical composition and antimicrobial activity of essential oil from the leaves of Artemisia vulgaris L. Molecules 28:2279. doi: 10.3390/molecules28052279
Stenfors Arnesen, L. P., Fagerlund, A., and Granum, P. E. (2008). From soil to gut: Bacillus cereus and its food poisoning toxins. FEMS Microbiol. Rev. 32, 579–606. doi: 10.1111/j.1574-6976.2008.00112.x
Techer, C., Baron, F., Delbrassinne, L., Belaïd, R., Brunet, N., Gillard, A., et al. (2014). Global overview of the risk linked to the Bacillus cereus group in the egg product industry: identification of food safety and food spoilage markers. J. Appl. Microbiol. 116, 1344–1358. doi: 10.1111/jam.12462
Tewari, A., Singh, S. P., and Singh, R. (2015). Incidence and enterotoxigenic profile of Bacillus cereus in meat and meat products of Uttarakhand, India. J. Food Sci. Technol. 52, 1796–1801. doi: 10.1007/s13197-013-1162-0
Trinh, P. T. N., Truc, N. C., Danh, T. T., Trang, N. T. T., Le Hang, D. T., Vi, L. N. T., et al. (2024). A study on the antioxidant, anti-inflammatory, and xanthine oxidase inhibitory activity of the Artemisia vulgaris L. extract and its fractions. J. Ethnopharmacol. 334:118519. doi: 10.1016/j.jep.2024.118519
Vidic, J., Chaix, C., Manzano, M., and Heyndrickx, M. (2020). Food sensing: detection of Bacillus cereus spores in dairy products. Biosensors 10:15216. doi: 10.3390/bios10030015
Walsh, P. S., Metzger, D. A., and Higuchi, R. (1991). Chelex 100 as a medium for simple extraction of DNA for PCR-based typing from forensic material. BioTechniques 10, 506–513.
Webb, M. D., Barker, G. C., Goodburn, K. E., and Peck, M. W. (2019). Risk presented to minimally proc essed chilled foods by psychrotrophic Bacillus cereus. Trends Food Sci. Technol. 93, 94–105. doi: 10.1016/j.tifs.2019.08.024
Zhang, Z., Feng, L., Xu, H., Liu, C., Shah, N. P., and Wei, H. (2015). Detection of viable enterotoxin-producing Bacillus cereus and analysis of toxigenicity from ready-to- eat foods and infant formula milk powder by multiplex PCR. J. Dairy Sci. 99, 1047–1055. doi: 10.3168/jds.2015-10147
Keywords: B. cereus, foodstuffs, virulence genes, antibiotic resistance, biofilm, Artemisia vulgaris extract, antibacterial activity, antioxidant
Citation: Fareid MA, El-Sherbiny GM, Elafandy NM, Eltoum NE, Othman MS, Sharaf MH, Abu-Elghait M, Elkhashab DM and Hamada FA (2025) Assessment of the risk associated with Bacillus cereus isolates and potential combat with methanolic Artemisia vulgaris extract. Front. Microbiol. 16:1640200. doi: 10.3389/fmicb.2025.1640200
Received: 04 June 2025; Accepted: 23 September 2025;
Published: 28 October 2025.
Edited by:
Daniel F. M. Monte, North Carolina State University, United StatesReviewed by:
Marina Spinu, University of Agricultural Sciences and Veterinary Medicine of Cluj-Napoca, RomaniaEnas Eltamany, Suez Canal University, Egypt
Copyright © 2025 Fareid, El-Sherbiny, Elafandy, Eltoum, Othman, Sharaf, Abu-Elghait, Elkhashab and Hamada. This is an open-access article distributed under the terms of the Creative Commons Attribution License (CC BY). The use, distribution or reproduction in other forums is permitted, provided the original author(s) and the copyright owner(s) are credited and that the original publication in this journal is cited, in accordance with accepted academic practice. No use, distribution or reproduction is permitted which does not comply with these terms.
*Correspondence: Mohamed A. Fareid, bS5hbGVraHRhYnlAdW9oLmVkdS5zYQ==; Gamal M. El-Sherbiny, Z2FtYWxlbHNoZXJiaW55MTk3MEB5YWhvby5jb20=; Z2FtYWxlbHNoZXJiaW55MTk3MEBhemhhci5lZHUuZWc=
†ORCID: Mohamed A. Fareid orcid.org/0000-0003-2703-617X
Gamal M. El-Sherbiny orcid.org/0000-0003-3968-0536
 Mohamed A. Fareid
Mohamed A. Fareid Gamal M. El-Sherbiny
Gamal M. El-Sherbiny Nancy M. Elafandy1
Nancy M. Elafandy1 Nagat E. Eltoum
Nagat E. Eltoum Mohamed S. Othman
Mohamed S. Othman Mohamed H. Sharaf
Mohamed H. Sharaf Mohammed Abu-Elghait
Mohammed Abu-Elghait Dina M. Elkhashab
Dina M. Elkhashab Fatma A. Hamada
Fatma A. Hamada








